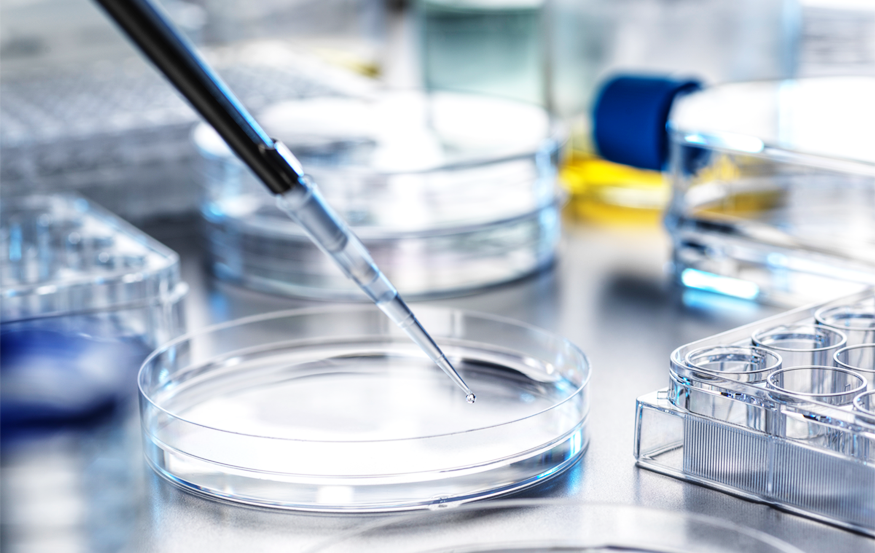

Digital Anatomy &
Educational Technology

Seo Yi Choi, Dong Hyeok Choi, Sung Ho Cho, So Hyun Ahn, Seung Ho Han.
Anatomy Education Potential of the First Digital Twin of a Korean Cadaver. PLoS One. 2025; 3.
Seo Yi Choi, Dong Hyeok Choi, Sung Ho Cho, So Hyun Ahn, Seung Ho Han.
Development and Utilization of 3D Anatomy Education Content using Metaverse and XR for Remote Telemedicine
Education. bioRXiv. 2024; 6.
Bae JS, Kim GY, Kim HJ, Han SH, Youn KH
Comparison of anatomy image generation capability in AI image generation models. J Vis Commun Med.
2025 May 23:1-8.
Oh SM, Kim JY, Han S, Lee W, Kim I, Hong G, Oh W, Moon H, Seo C
Development and Usability of a Virtual Reality-Based Filler Injection Training System. Aesthetic Plast Surg.
2020 Oct;44(5):1833-1842.
Craniofacial &
Plastic Surgery Anatomy


Jeon A, Hwang K, Han SH. Nebuchadnezzar's Transformation Related to Modern Plastic Surgery. J Craniofac Surg. 2025 Apr 29.
Jeon A, Hwang K, Han SH. Portrayal of the Idealized, Mythical Beauty of Medieval Europe: Isolde the Fair in Tristan and Isolde. J Craniofac Surg. 2025 May 29.
Jeon A, Hwang K, Han SH. Della Porta’s Physiognomy and Its Influence on Plastic Surgery. Journal of Craniofacial Surgery Open 3(2):e0028, June 2025.
Jung SG, Wu X, Hwang K, Han SH. Anthropometric analysis of the faces of Chinese beauty pageant winners, from the early 20th century to the present. J Craniofac Surg. 2024 Feb 16.
Hwang K, Lee SI, Han SH. Freeing and Stretching the Palatine Vessels From the Greater Palatine Foramen in Palatoplasty. J Craniofac Surg. 2023 Dec 6.
Kim YG, Jeon A, Hwang K, Chung YH, Han SH. The Distribution of the Nerves and Arteries of the Platysma for Clinical Applications. J Craniofac Surg. 2023 Oct 1;34(7):2206-2211.
Hwang K, Han SH. Digital Compression of the Origin of the Nasal Branch of the Ophthalmic Artery During Filler Augmentation: A Review of the Anatomical Literature and an Analysis of Plastinated Specimens. J Craniofac Surg. 2023 Oct 1;34(7):e692-e694.
Kim YG, Jeon A, Sui HJ, Hwang K, Han SH. Morphological Boundaries of the Parotid Gland in Koreans. J Craniofac Surg. 2021 Jul-Aug 01;32(5):1918-1922.
Aging of the bony orbit in East Asians: a three-dimensional computed tomographic study. Surgical and Radiologic Anatomy.1-10. (2020)
Platysmaplasty: Is it Possible to Pull the Platysma Effectively in the Medial or Lateral Direction? Journal of Craniofacial Surgery. 31(1), 303-305. (2020)
Relationship of the lobular branch of the great auricular nerve to the tympanoparotid fascia: Spatial anatomy for salvage during face and neck lift. PloS one. 14(10). (2019)
Anatomical changes in the East Asian midface skeleton with Aging. Folia Morphologica. 76(4): 730-5. (2017)
Anatomy of the Tenth Costal Cartilage for a Columella Strut in an Asian Rhinoplasty. Journal of Craniofacial Surgery. 26(3): 927-9. (2015)
Where to fix in rejuvenation surgeries?: tensile strength of the periosteum. The Journal of Craniofacial Surgery. 26(1): 248-250. (2015)
Skin Tension Related to Tension Reduction Sutures. The Journal of Craniofacial Surgery. 26(1): e48-e50. (2015)

Clinical Anatomy &
Injection Techniques

Kim YG, Chung YH, Ahn HJ, Jeon A, Kim YS, Hwang K, Han SH. Thickness of the Deltoid Muscle and Location of the Anterior Branch of the Axillary Nerve and the Posterior Circumflex Humeral Artery for Deltoid Injections. Biomed Res Int. 2022 Dec 15;2022:1784572.
Botulinum Toxin Injection-Site Selection for a Smooth Shoulder Line: An Anatomical Study. BioMed Research International. 1-5. (2017)
Investigating Skin Penetration Depth and Shape Following Needle-Free Injection at Different Pressures: A Cadaveric Study. Lasers in surgery and medicine. 48(6): 624-8. (2016)
Pneumatic Injection Therapy-Induced Transcutaneous Penetration of Hypertonic Glucose Solution: Macro- and Microscopic Analyses of Human and Rat Tissues. MEDICAL LASERS. 7(1):13-20. (2018)
Craniofacial &
Plastic Surgery Anatomy


Kim YH, Park I, Cho SB, Yang S, Kim I, Lee KH, Choi K, Han SH. Three-Dimensional Virtual Reconstructions of Shoulder Movements Using Computed Tomography Images: Model Development. Interact J Med Res. 2023 Oct 5;12:e48381.
Uh S, Yoon N, Jung S, Lee J, Han S. Investigation of Successful Performance Training for Taekwondo Athletes: Literature Review. Ann Appl Sport Sci 2024; 12.
Effect of Structural Design on the Pullout Strength of Suture Anchors for Rotator Cuff Repair. Journal of Orthopaedic Research. (2018)
The Distribution Pattern of the Neurovascular Structures for Anterior Ankle Arthroscopy to Minimize Structural Injury: Anatomical Study. BioMed Research International. 1-5. (2018)
High-Pressure Balloon-Assisted Stretching of the Coracohumeral Ligament to Determine the Optimal Stretching Positions: A Cadaveric Study. PM&R. 8(10): 925-34. (2016)
Primary Stability of Inferior Tilt Fixation of the Glenoid Component in Reverse Total Shoulder Arthroplasty: A Finite Element Study. Journal of Orthopaedic Research. 34(6):1061-8. (2016)
An Arthroscopic Safety Zone for the Medial Compartment of the Hip Joint. Surgical and Radiologic Anatomy. 37(8): 969-74. (2015)
Inferior tilt fixation of the glenoid component in reverse total shoulder arthroplasty: A biomechanical study. Orthopaedics & Traumatology: Surgery & Research. 101(4): 421-5. (2015)
The Size of the Rotator Cuff and the Positional Relationship of BonyLandmarks: An Anatomical Study. Korean J Phys Anthropol. 28(1): 11-17. (2015)
Effect of baseplate size on primary glenoid stability and impingement-free range of motion in reverse shoulder arthroplasty. BMC Musculoskelet Disord. 15(417): 1-7. (2014)
Forensic &
Anthropological Anatomy

Comprehensive evaluation of the greater sciatic notch for sexual estimation through three-dimensional metric analysis using computed tomography based models. Legal Medicine. (2018)
Selecting best-fit models for estimating the body mass from 3D data of the human calcaneus. Forensic Science International. 262: 37-45. (2016)
Non-metric Study of the External Occipital Protuberance for Sex Determination in Koreans: Using Three-dimensional Reconstruction Images. The Korean Journal of Physical Anthropology. 28(4): 239-45. (2015)
Sex Determination Using Upper Limb Bones in Korean Populations. Anatomy & Cell Biology. 47(3): 196-201. (2014)
Stature estimation from partial m...31891 bytes truncated... (2014)
Neuroanatomy &
Muscle Innervation


The universal existence of myodural bridge in mammals: an indication of a necessary function. Scientific Reports. 7: 1-9. (2017)
The second terminations of the suboccipital muscles: An assistant pivot for the To Be Named Ligament. PLoS One. 12(5): 1-8. (2017)
Innervation of Subclavius Muscle: An Anatomical Study. International Journal of Morphology. (2018)
Distribution of the internal branch of the human accessory nerve. Anatomical Science International. 90(3): 180-6. (2015)
Morphological characteristics of the cranial root of the accessory nerve. Clinical Anatomy. 27(8): 1167-73. (2014)

Vascular Anatomy

A rare branching pattern of hindgut: absence of inferior mesenteric artery. Surgical and Radiologic Anatomy. 39(7): 803-6. (2017)
Neurovascular distribution within the abdominal head of the pectoralis major muscle: Application to breast and flap surgery. Clinical Anatomy. 28(4): 520-6. (2015)
Medical Education &
Illustration


Choi SC, Wu X, Hwang K, Kim H, Han SH. Illustrations in the Journal of Craniofacial Surgery. J Craniofac Surg. 2020 Jul-Aug;31(5):1370-1372.
Clinical Neuroanatomy and Neuroscience (5th Ed., E*Public) (2008)
Systemic Anatomy (2nd Ed., Korea Medical Book Publisher) (2007)
Wolf-Heidegger's Atlas of Human Anatomy (Korean Ed., E*Public) (2006)
Guide Book for Cadaver Dissection (5th Ed., Soo Moon Sa) (2005)
Regional Anatomy (2nd Ed., Korea Medical Book Publisher) (2005)
Basic Anatomy (5th Ed., Tamgu-Dang) (2005)
Atlas of Human Anatomy Sobotta Vol. 1, 2 (Korean Ed., Sinheung Medscience, Inc.) (2004)